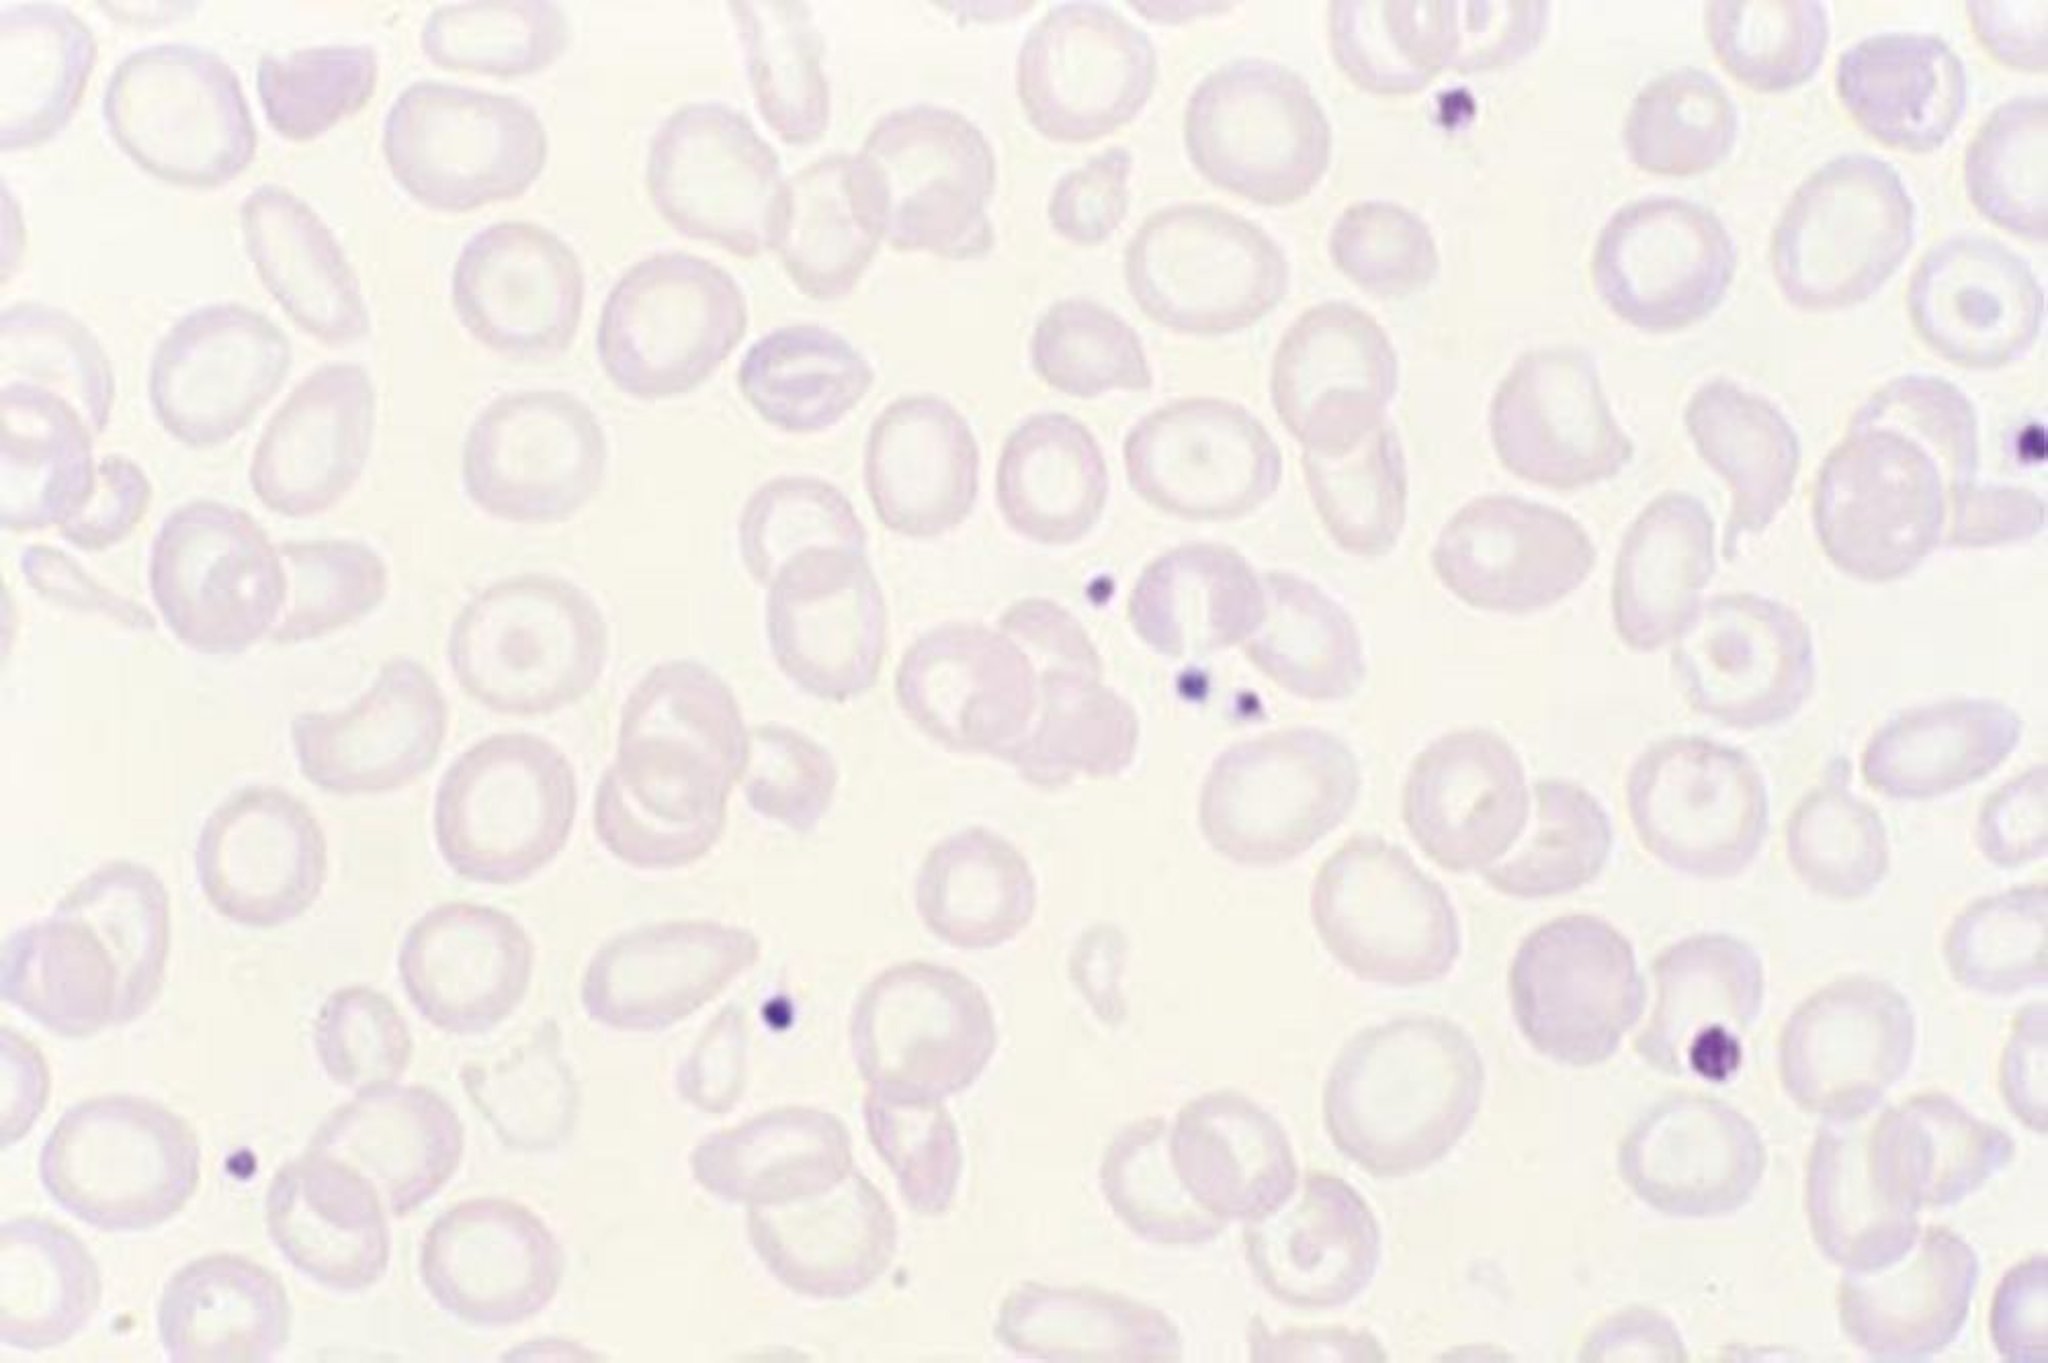
Cellule a bersaglio

Cellule a bersaglio
Le cellule bersaglio (globuli rossi sottili con un punto centrale di emoglobina; freccia) sono dovute a uno squilibrio tra il volume della cellula e il suo contenuto di emoglobina e caratterizzano la talassemia, altre emoglobinopatie (p. es., la malattia da emoglobina C e la malattia da emoglobina S-C) ma possono anche verificarsi dopo la splenectomia e nella malattia epatica.
By permission of the publisher. From Tefferi A, Li C. In Atlas of Clinical Hematology. Edited by JO Armitage. Philadelphia, Current Medicine, 2004.
In questi argomenti